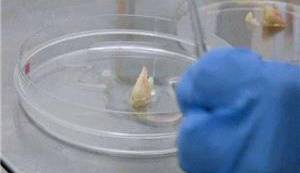
تولید مینای بیولوژیکی دندان به کمک سلول‌های بنیادی

نانوسیم ها انتقال سلول های بنیادی به استخوان را تسریع می کنند
یک پلتفرم نانوتکنولوژی توسعه یافته، کشف کرده است که انتقال سلول های بنیادی به استخوان [...]
عکس آینهای کهکشان در لنز گرانشی
تصویری که ماموریت هابل در این هفته از این تلسکوپ فضایی منتشر کرده است، تاثیر [...]
تصاویر حیرتانگیز از مریخ که شما را برای سفر به سیاره سرخ وسوسه میکنند!
گفتنی است که با چراغ سبز اداره هوانوردی فدرال آمریکا جهت بلند شدن استارشیپ از [...]
تولید مینای بیولوژیکی دندان به کمک سلولهای بنیادی
محققان موفق شدند سلولهای بنیادی دندان انسان را به آملوبلاستها تبدیل کنند که میتوان از [...]
گامی مهم در علم دندانپزشکی؛ ایجاد مینای دندان با سلولهای بنیادی
تا به امروز، آسیب به مینای دندان و حفرهها توسط دندانپزشکان و با استفاده از [...]
تاثیر اَبَرقارهها بر روی زمین
تحقیقات جدید توسط دانشمندان دانشگاه آدلاید استرالیا، نشان داده است که چرا اکلوژیتها در مراحل [...]
تبدیل سلولهای بنیادی به سلولهای استخوانی
دانشمندان دانشگاه RMIT توانستهاند با استفاده از امواج مکانیکی با فرکانس بالا (در حد مگاهرتز)، [...]
تبدیل سلول های بالغ به سلول های بنیادی پرتوان
محققان دانشگاه هلسینکی تکنیکی را کشف کردند که می تواند سلول های بالغ را به [...]